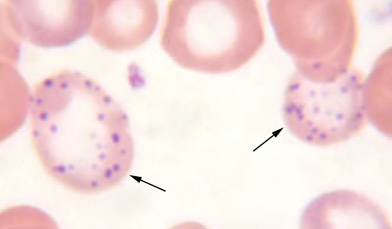

What is the main difference in effect between unfractioned heparin and LMWH?
Both of them can bid to AT3 to increase its activity against factor Xa.
Only unfractionated heparin is able to bind to both AT3 and thrombin, thereby allowing antithrombin to inactivate thrombin.
What is the most common viral cause for aplastic crisis for sickle cell patients?
Parvovirus B19
What effect might fibrinolytics have on heart rhythm?
They may cause a repurfusion arrhythmia on arterial reopening. These arrhytmias are usually benign.
What is the presentation for Hemolytic Uremic Syndrome? (3) What is the etiology?
Result of 0157:H7 E.coli, usually in undercooked ground beef
Hepcidin
What is the effect of low hepcidin levels?
Low hepcidin levels increase intestinal iron absorptin and stimulate iron release by macrophages
Hairy Cell Leukemia
What is the specific deficiency in patients with Glanzmann thrombasthenia?
(GP) IIb/IIIa, needed for platelet aggregation
Abciximab MOA
It blocks the GP IIb/IIIa receptor, which normally promots platelet binding to fibrinogen
Paroxysmal nocurnal hemoglobinuria is result of an acquired mutation in what gene? What inhibitor proteins is absent and/or deficient as a result?
Mutation in the PIGA gene. This leads to absence of the GPI anchor that normally protects the RBC from complement, and associated deficiency of CD55/CD59 complement inhibitor proteins.
Dactylitis
(What is it and what is it a common presentation of?)
Painful swelling of the hands and feet
It is a common presentation of sickle cell in young children.
What effect does sickling (in SCD) have on labs?
Leads to
What drugs do you give to reverse heparin effects? Warfarin effects?
Heparin: protamine sulfate
Warfarin: Vitamin K and Fresh Frozen Plasma (FFP)
X-linked (Bruton) agammaglobulinemia
Distinguish Precursor B-ALL from precursor T-ALL
This can only be done via immunophenotyping
B-ALL: TdT+, CD10+ and CD19+
T-ALL: TdT+, CD1a+, and + for T-cell markers (CD2 , 3, 4, 5, 7, and 8)
What is the role of atypical T-cells in assc. with EBV?
They function to destroy virally-infected B-lymphocytes
Patients with Down Syndrome are at an increased risk for what CA types?
ALL and AML
Tumor lysis syndrome
Prevention of Tumor Lysis Syndrome
Prevent w/ hydration + use of hypouricemic agents such as allopurinol or rasburicase
Describe the peripheral blood smear associated with lead poisoning
Coarse erythrocyte basophilic stippling and microcytic hypochromic anemia
(Leukocyte Accumulation:) What receptors are involved in:
What is the primary site for complement production?
The liver
Pure Red Cell Aplasia